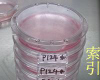

|
||




 |
||

編號
26000
品名
新型細胞培養皿
規格
9020-C(細胞培養用)1箱200個。
1袋10個。
新型細胞用培養皿,向上提升的機能性和作業性.
.jpg) 索引:新型書寫在本體側邊,容易管理不會出錯.
索引:新型書寫在本體側邊,容易管理不會出錯.
 鎖定功能:旋轉上蓋可鎖定本體,防止不經意的落下.
鎖定功能:旋轉上蓋可鎖定本體,防止不經意的落下.  一指開啟:可一指打開上蓋,不需整個打開,減輕污染.可固定上蓋.
一指開啟:可一指打開上蓋,不需整個打開,減輕污染.可固定上蓋.
防止污染:和舊型不同的上蓋,本體設計,可有效防止污染.
TPX培養皿
 全透明. 附蓋. 可高壓滅菌.
全透明. 附蓋. 可高壓滅菌.
|
編號
|
外徑
|
全高
|
|
2361
|
90mm
|
20mm
|